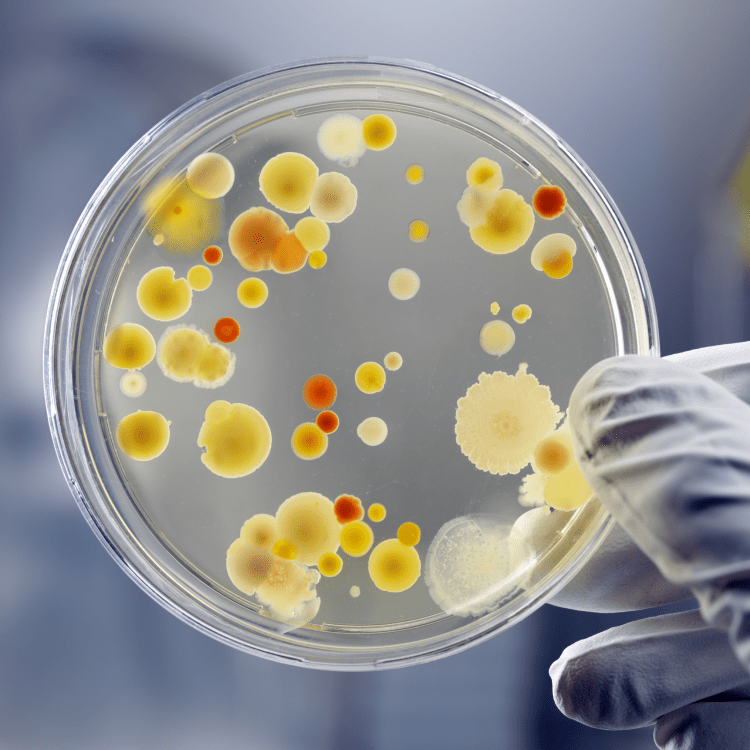

We specialise in a variety of difference products that cover a wide industry.
Performance Antimicrobials

Ultra-Fresh is a portfolio of antimicrobial treatments developed by Microban with over 60 years of antimicrobial expertise. Today, Ultra-Fresh technologies are used by hundreds of manufacturers in more than 50 countries. Expert, through and timely technical service are key reasons manufacturers from around the world place their trust in Ultra-Fresh.
Antimicrobial Applications
Delivering lasting freshness and longer life to consumers and industrial products, Ultra-Fresh antimicrobial treatments can be used in virtually any end-use application. A few examples include textiles, plastics, coating, foam and more.

The Benefits of Ultra-Fresh
- Easily applied at the point of manufacture to become an integral feature of treated goods.
- Prevents doors, staining and degradation caused by bacteria, mould and mildew.
- Provides a durable finish and works continuously so products stay clean and fresh.
- Offers a competitive edge and an economical means of increasing value and performance.
- Enhances product quality, avoiding costly recalls and product replacement due to microbial growth.
- Extends the useful life of treated goods, promoting environmental responsibility.
For learn more visit https://ultra-fresh.com
Flame Retardant Compounds


Our key focus is to provide Halogen Free flame retardants for a safer and environmentally better choice. We provide these knowing the flame retardant efficiency will not be compromised meeting stringent international standards.
Our main partner is CTF2000, Belgium a globally recognised Belgium based organisation for its product quality and environmental stewardship.
To learn more visit www.ctf2000.com
Specialty Acrylic Polymers





XYNTRA Chemicals UK, is focused on the polymerisation of acrylic homopolymers and copolymer binders and resins.
To learn more on specific product information and application details visit https://www.xyntra.com





ADDAPT Chemicals, Netherlands, manufactures specialty additives for the paint, coatings, food and lubricant markets.
For learn more on specific product information visit http://www.addapt-chem.com/index.html